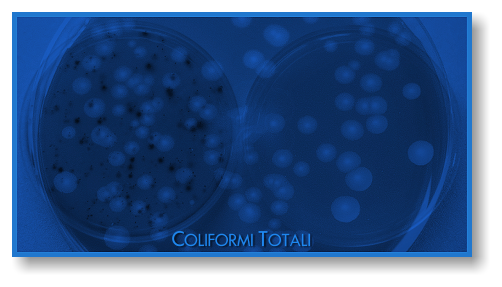

Analisi Microbiologiche 1 - ALIMENTAZIONE AMBIENTE Srl - Laboratorio ChimicoMicrobiologico - Roma (Italy)
Menu principale:
Analisi Microbiologiche 1
ANALISI
Analisi Microbiologiche 1

ANALISI MICROBIOLOGICHE DI ALIMENTI
Le prove di laboratorio inerenti le analisi microbiologiche hanno lo scopo di individuare negli alimenti, oltre la carica microbica complessiva, gli indicatori igienici (Coliformi totali, Coliformi fecali, Escherichia coli, Enterobacteriacee, Enterococchi) e i patogeni (Stafilococco aureo, Salmonelle, Listeria monocytogenes, ecc.) al fine di un giudizio di qualita' igienica o di prevenzione da eventuali infezioni o tossinfezioni alimentari; inoltre risultano utili per determinare la conservabilita' o la shelf life di alimenti cotti e conservati refrigerati sottovuoto o in atmosfera modificata.

ALIMENTI
(PARAMETRO)
- Anaerobi solfito riduttori
- Bacillus cereus

- Brucelle
- Candida albicans

- Carica microbica totale (germi mesofili a 20 gradi C)
- Carica microbica totale (germi mesofili a 32 gradi C)
- Carica microbica totale (germi mesofili a 37 gradi C)
- Carica microbica totale (in anaerobiosi a 37 gradi C)
- Carica microbica totale (psicrofili a 6,5 gradi C)
- Coliformi totali
- Escherichia coli

- Ricerca del Clostridium perfrigens
- Ricerca del Clostridium botulinum

- Riconoscimento delle muffe
- Salmonelle e Shigelle


- Spore mesofile aerobie
- Spore mesofile anaerobie
- Spore termofile anaerobie
- Conta di germi lipolitici
- Stafilococco coagulasi (+)
- Muffe e Lieviti
- Legionella
- Lattobacilli
- Micobatteri
- Micrococcaceae totali

- Pseudomonas aeruginosa
- Streptococchi fecali
- Listeria quantitativa
- Listeria qualitativa

